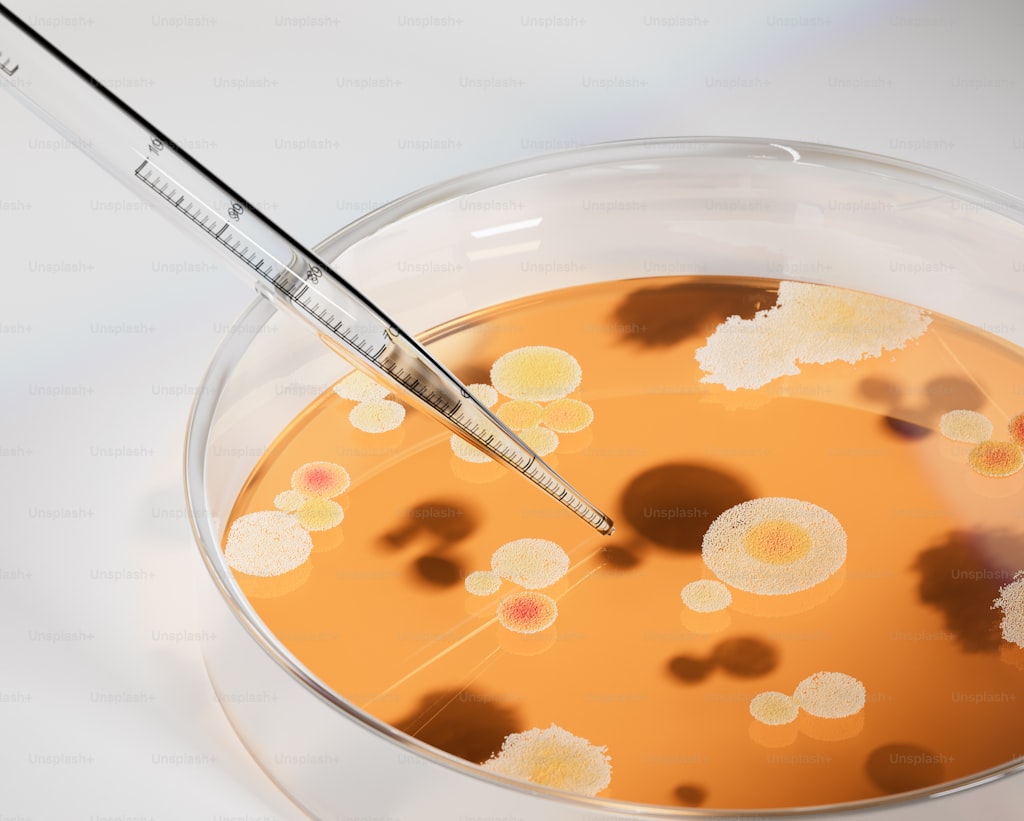
Typecho插件开发方案 Statistician（统计师）

Typecho插件开发方案 Statistician(统计师)
这个插件将实现文章置顶、浏览量统计、自定义字段点击统计三大功能,并📦 插件名称:Statistician(统计师)一、插件功能概述功能模块具体实现技术特点文章置顶后台文章编辑页添加置顶开关,支持多篇文章置顶基于Sticky插件思路,扩展字段标记文章浏览量自动记录文章被浏览次数,支持防刷机制独立数据表存储,Cookie防刷自定义字段统计统计任意自定义字段(如下载链接)的点击次数动态路由+异步请求,可扩展性强二、数据库设计创建独立数据...